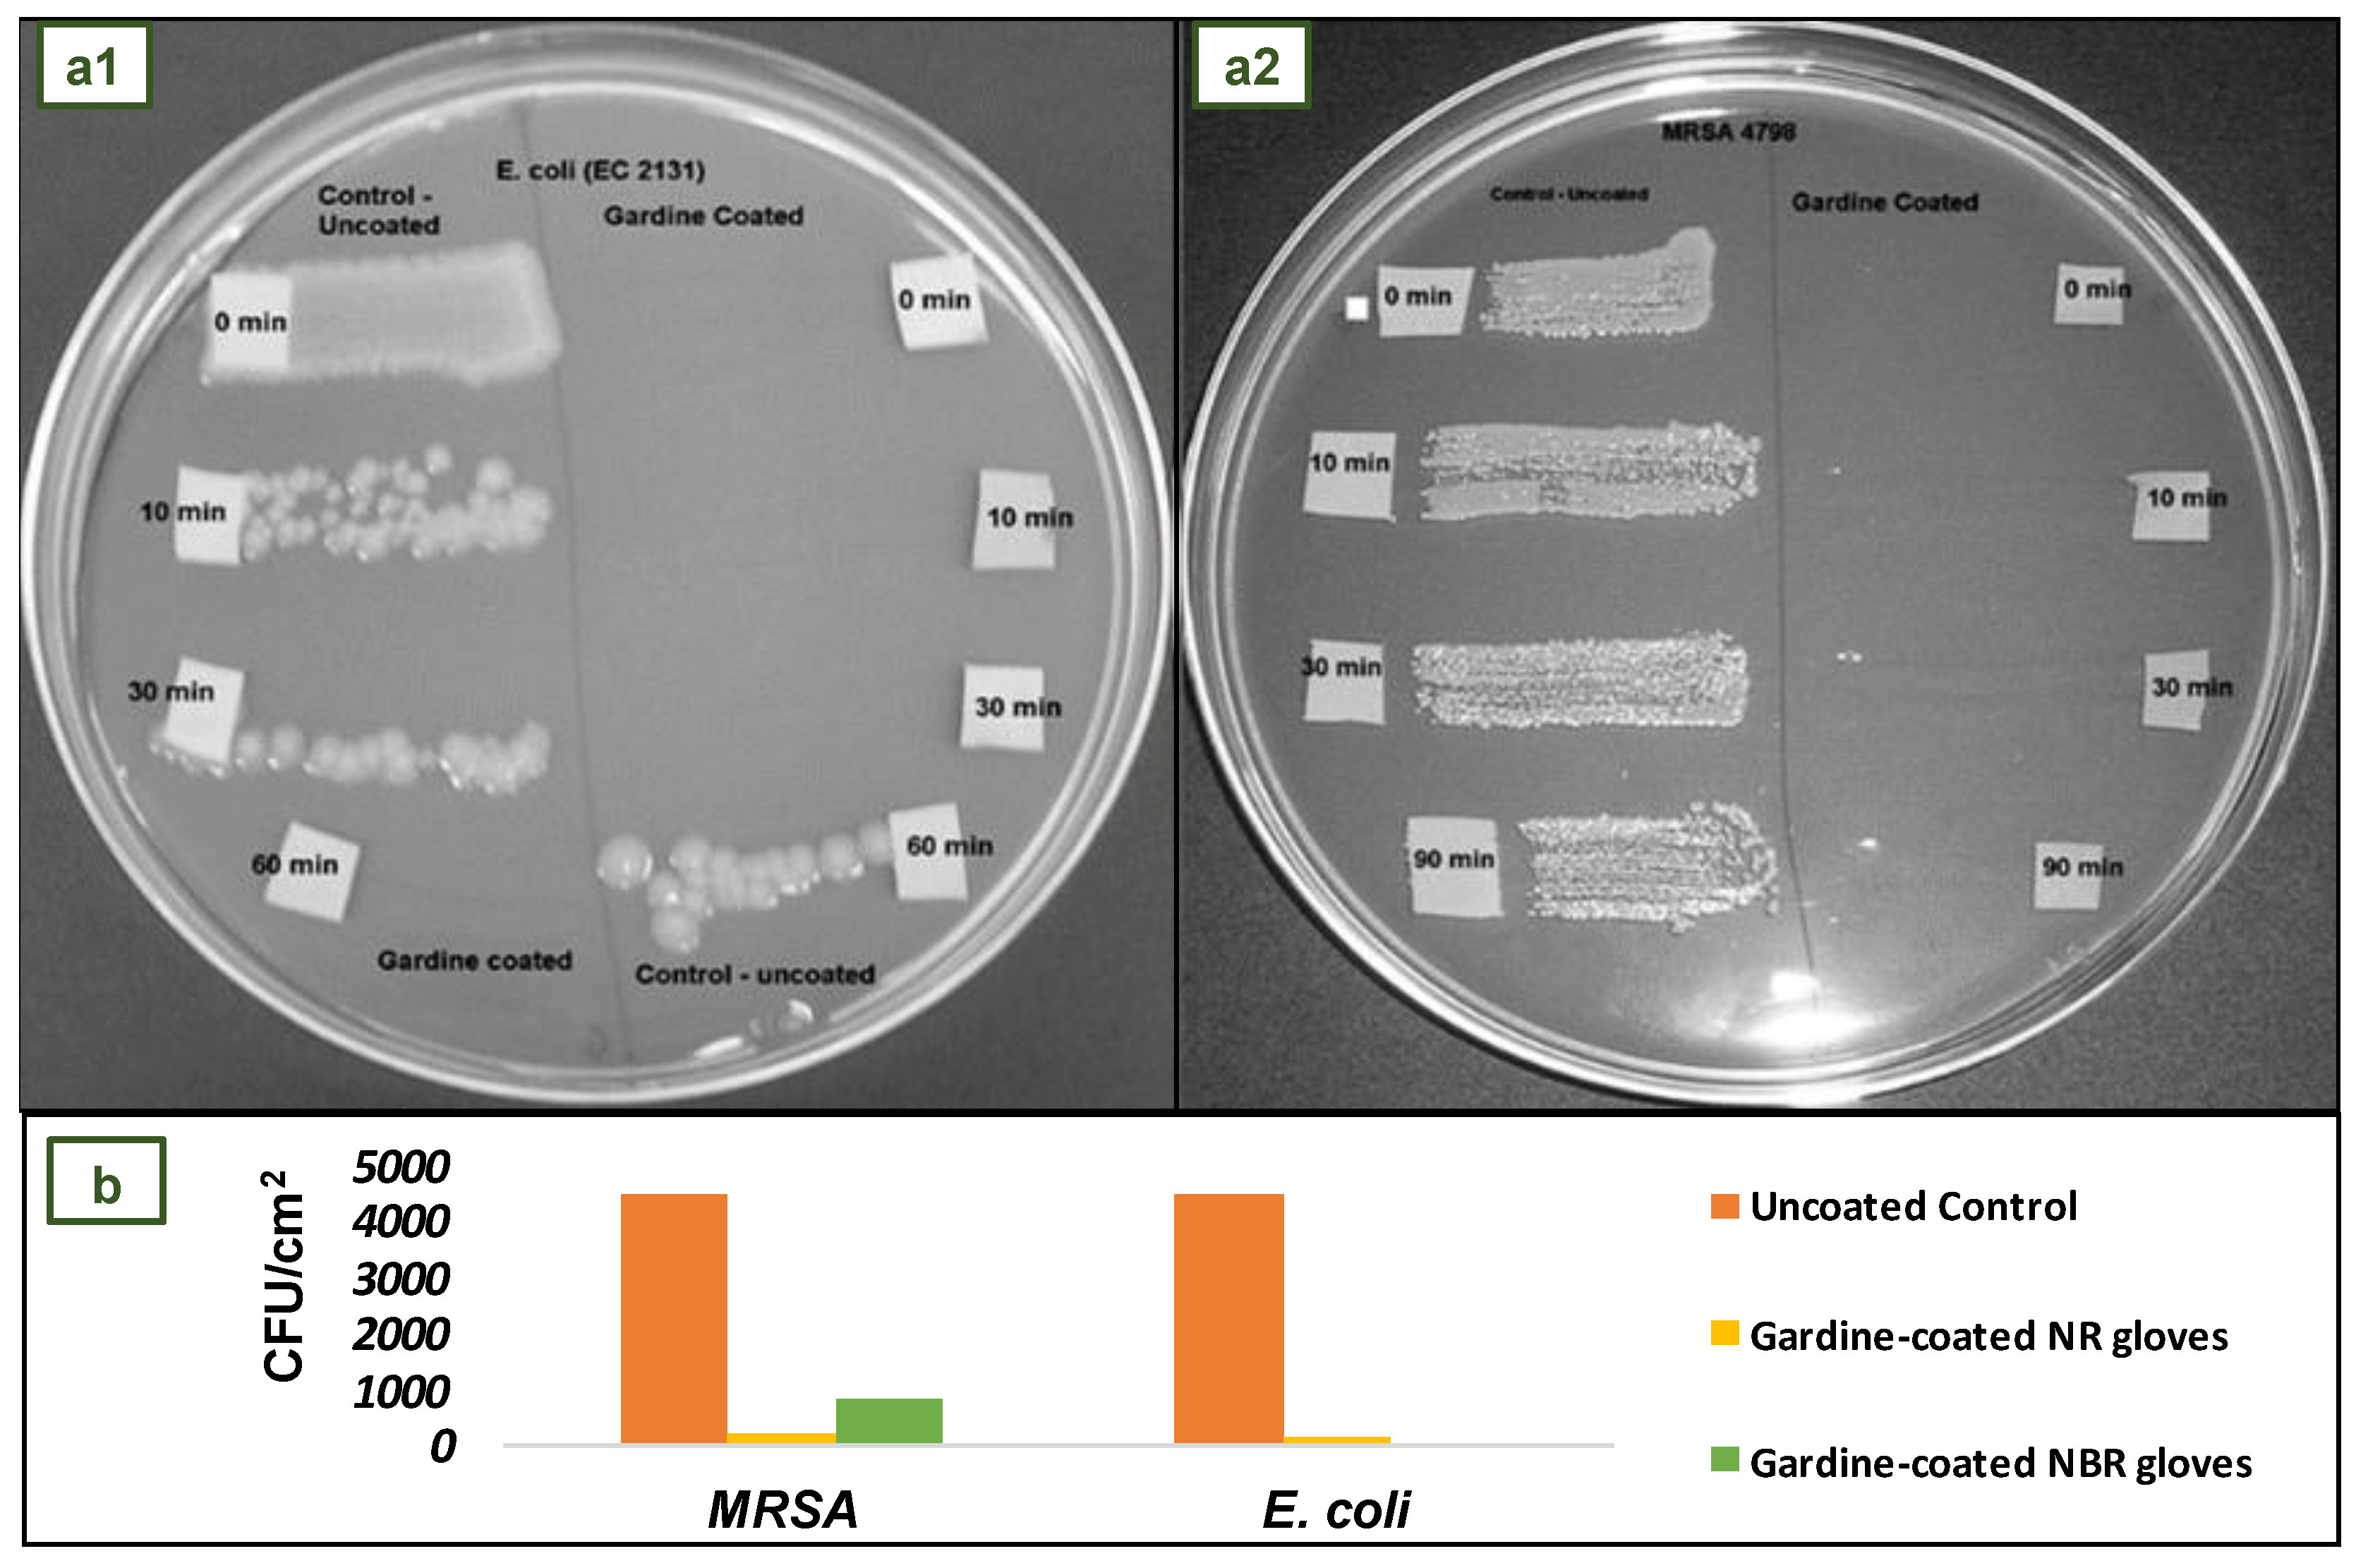
Jfb 14 00349 g013

Performance-Enhancing Materials in Medical Gloves
Abstract
1. Introduction
1.1. History of Medical Gloves
1.2. Market of Medical Gloves
1.3. Production Process of Medical Gloves
1.4. Environmental Concerns Related to Medical Gloves
2. Types of Medical Gloves
2.1. Natural Rubber (NR)
2.2. Polyisoprene (IR)
2.3. Acrylonitrile Butadiene Rubber (NBR)
2.4. Polychloroprene (CR)
2.5. Polyethylene (PE)
2.6. Poly(vinyl Chloride) (PVC)
3. Mechanical Properties of Medical Gloves
4. Prototypes of Medical Gloves with Performance-Enhancing Materials
4.1. Biodegradable Green Gloves Containing Ascorbic Acid from Maleate Epoxidized Natural Rubber/Poly(vinyl Alcohol) Blend
4.2. NR Films/Gloves and Carboxylated-NBR (XNBR) Films Containing Sago Starch as Bio-Filler
4.3. Mangosteen Peel as Antimicrobial Agent in NR Gloves
4.4. NR Films with Cellulose Nanocrystals as Reinforcing and Crosslinking Agent for Application in Gloves
4.5. NR and NBR Gloves Coated with Gardine Solution
4.6. NBR Gloves Coated with Poly(hexamethylene Biguanide) Hydrochloride
4.7. NR Antimicrobial Three-Layer Glove
4.8. NBR Antimicrobial Gloves Coated with Electrospun Trimethylated Chitosan (TMCh)-Loaded (PVA) Fibers
4.9. Antibacterial NR Films with Surface-Anchored QP4-VP for Application in Medical Gloves
4.10. NR, NBR, and PE Medical Gloves with Blood-Repellent, Antibacterial, and Wound Healing Properties, Modified through Spraying Process
4.11. NR Gloves with SiO2 and ZnO Hybrid Nanofillers
4.12. NR Antimicrobial Gloves Impregnated with Biosynthesized Silver Nanoparticles
4.13. NR Antimicrobial Gloves with Poly(dimethylsiloxane)-Copper Coating
5. Conclusions
Author Contributions
Funding
Acknowledgments
Conflicts of Interest
References
- Mazón, L.; Orriols, R.M. Sanitary Gloves Management. Adequate Protection-Effectiveness and Environmental Responsibility. Rev. Asoc. Española Espec. Med. Trab. 2018, 27, 175–181. [Google Scholar]
- Delves, P.J.; Martin, S.J.; Burton, D.R.; Roitt, I.M. Roitt’s Essential Immunology, 13th ed.; John Wiley and Sons: Hoboken, NJ, USA, 2017; ISBN 9781118415771. [Google Scholar]
- Ford, C.; Park, L.J. How to Apply and Remove Gloves. Br. J. Nurs. 2019, 28, 26–28. [Google Scholar] [CrossRef]
- Babadi, A.A.; Bagheri, S.; Hamid, S.B.A. Progress on Antimicrobial Surgical Gloves: A Review. Rubber Chem. Technol. 2016, 89, 117–125. [Google Scholar] [CrossRef]
- Ellis, H. Surgical Gloves. J. Perioper. Pract. 2010, 20, 219–220. [Google Scholar] [CrossRef]
- Ellis, H. Evolution of the Surgical Glove. J. Am. Coll. Surg. 2008, 207, 948–950. [Google Scholar] [CrossRef]
- Carraher, C.E. Introduction to Polymer Chemistry, 4th ed.; CRC Press: Boca Raton, FL, USA, 2017; ISBN 978-1-4987-3761-6. [Google Scholar]
- Ikeda, Y. Understanding Network Control by Vulcanization for Sulfur Cross-Linked Natural Rubber (NR). Chem. Manuf. Appl. Nat. Rubber 2014, 2014, 119–134. [Google Scholar] [CrossRef]
- Boyd, D.A. Sulfur and Its Role In Modern Materials Science. Angew. Chem. 2016, 128, 15486–15502. [Google Scholar] [CrossRef] [PubMed]
- Hill, D.M. The Science and Technology of Latex Dipping, 1st ed.; Smithers Rapra: Shrewsbury, UK, 2018; ISBN 9781909030053. [Google Scholar]
- von Manteuffel, W.Z. Rubber Gloves in the Practice of Surgery. Cent. Surg. 1897, 24, 553–556. [Google Scholar]
- Palma, S. How the World’s Largest Maker of Rubber Gloves Is Coping with Covid|Financial Times. Available online: https://www.ft.com/content/359047c2-89fb-11ea-a109-483c62d17528 (accessed on 10 October 2022).
- Kim Man, M.M. Glove Industry Spikes during Covid-19 Pandemic: A Case Study of Comfort Gloves Berhad (CGB). Int. Bus. Res. 2021, 14, 105. [Google Scholar] [CrossRef]
- Ugalmugle, S.; Swain, R. Medical Gloves Market Size by Product, by Form, by Application, by Usage, by Sterility, by Distribution Channel, by End-Use, COVID-19 Impact Analysis, Regional Outlook, Growth Potential, Price Trends, Competitive Market Share & Forecast, 2021–2027. Available online: https://www.gminsights.com/industry-analysis/medical-gloves-market (accessed on 4 July 2022).
- Grand View Research Disposable Gloves Market Size Report, 2022–2030. Available online: https://www.grandviewresearch.com/industry-analysis/disposable-gloves-market (accessed on 9 March 2023).
- Eurostat EU Trade since 2015 of COVID-19 Medical Supplies by Categories. Available online: https://appsso.eurostat.ec.europa.eu/nui/submitViewTableAction.do (accessed on 8 June 2022).
- Kanjanavisut, K. COVID-19 Increased Global Demand for Medical Glove. EIC Indicates That Malaysia Gains More from Export Than Thailand. Available online: https://www.scbeic.com/en/detail/file/product/6857/fnyoncnigx/EIC-Note_rubber-glove_EN_20200601.pdf (accessed on 29 April 2023).
- Tey, C. MARGMA Expects Global Glove Demand to Resume Growth Next Year, after 19% Drop|The Edge Markets. Available online: https://www.theedgemarkets.com/article/margma-expects-global-glove-demand-resume-growth-next-year-after-19-drop (accessed on 7 October 2022).
- MarketWatch Disposable Gloves Market 2022 Recent Developments, Size, Share, Growth Strategies, Segment by Type, Region and Future Forecast 2028—MarketWatch. Available online: https://www.marketwatch.com/press-release/disposable-gloves-market-2022-recent-developments-size-share-growth-strategies-segment-by-type-region-and-future-forecast-2028-2022-08-01 (accessed on 7 October 2022).
- Lim, J. Top Glove Makes the Highest Quarterly Profit among Malaysia’s Top 10 Companies|The Edge Markets. Available online: https://www.theedgemarkets.com/article/top-glove-makes-highest-quarterly-profit-among-malaysias-top-10-companies (accessed on 10 October 2022).
- Wong, E.L. Top Glove Posts Record Net Profit of RM348m in 3Q, Declares 10 Sen Dividend|The Edge Markets. Available online: https://www.theedgemarkets.com/article/top-glove-posts-record-3q-net-profit-rm348m-declares-10-sen-dividend (accessed on 10 October 2022).
- Syafiqah, S. Comfort Gloves Quarterly Net Profit Declines on Two Fronts|The Edge Markets. Available online: https://www.theedgemarkets.com/article/comfort-gloves-quarterly-net-profit-declines-two-fronts (accessed on 10 October 2022).
- Kuala Lumpur Stock Exchange (KLSE) COMFORT (2127): Quarterly Results for Last 10 Financial Years|I3investor. Available online: https://klse.i3investor.com/web/stock/financial-quarter/2127 (accessed on 10 October 2022).
- Sajeev, S.; Chandra, G. Disposable Gloves Market Size, Share, Trends & Industry Analysis 2023. Available online: https://www.alliedmarketresearch.com/disposable-gloves-market (accessed on 19 May 2020).
- Maximize Market Research Nitrile Gloves Market: Global Industry Analysis and Forecast (2022–2029). Available online: https://www.maximizemarketresearch.com/market-report/nitrile-gloves-market/126531/ (accessed on 7 October 2022).
- Akabane, T. Production Method & Market Trend of Rubber Gloves. Int. Polym. Sci. Technol. 2016, 43, 369–373. [Google Scholar] [CrossRef]
- Crépy, M.-N.; Hoerner, P. Gloves: Types, Materials, and Manufacturing. In Protective Gloves for Occupational Use; CRC Press: Boca Raton, FL, USA, 2022; pp. 17–44. ISBN 9781003126874. [Google Scholar]
- Yip, E.; Cacioli, P. The Manufacture of Gloves from Natural Rubber Latex. J. Allergy Clin. Immunol. 2002, 110, S3–S14. [Google Scholar] [CrossRef]
- Wang, M.; Morris, M. Advances in Fillers for the Rubber Industry. In Rubber Technologist’s Handbook; White, J., De, S.K., Naskar, K., Eds.; Smithers Rapra Technology Limited: Shawbury, UK, 2009; Volume 2, pp. 189–214. ISBN 978-1-84735-100-5. [Google Scholar]
- Mellström, G.A.; Boman, A. Gloves: Types, Materials, and Manufacturing. In Protective Gloves for Occupational Use; Wahlberg, J.E., Boman, A., Estlander, T., Maibach, H.I., Eds.; CRC Press: Boca Raton, FL, USA, 2005; pp. 15–28. ISBN 9780367393854. [Google Scholar]
- Simpson, R.B. Rubber Basics; Rapra Technology Limited: Shrewsbury, UK, 2002; ISBN 185957307X. [Google Scholar]
- Srinivasan, S. Powdered Gloves: Time to Bid Adieu. J. Postgrad. Med. 2018, 64, 68. [Google Scholar] [CrossRef] [PubMed]
- Preece, D.; Hong Ng, T.; Tong, H.K.; Lewis, R.; Carré, M.J. The Effects of Chlorination, Thickness, and Moisture on Glove Donning Efficiency. Ergonomics 2021, 64, 1205–1216. [Google Scholar] [CrossRef]
- Daud, S.; You, Y.S.; Azura, A.R. The Effect of Acid Hydrolyzed Sago Starch on Mechanical Properties of Natural Rubber and Carboxylated Nitrile Butadiene Rubber Latex. Mater. Today Proc. 2019, 17, 1047–1055. [Google Scholar] [CrossRef]
- Rahman, M.F.A.; Rusli, A.; Adzami, N.S.; Azura, A.R. Studies on the Influence of Mixed Culture from Buried Soil Sample for Biodegradation of Sago Starch Filled Natural Rubber Latex Gloves. IOP Conf. Ser. Mater. Sci. Eng. 2019, 548, 012018. [Google Scholar] [CrossRef]
- Misman, M.A.; Azura, A.R. Overview on the Potential of Biodegradable Natural Rubber Latex Gloves for Commercialization. Adv. Mat. Res. 2013, 844, 486–489. [Google Scholar] [CrossRef]
- Jawjit, W.; Pavasant, P.; Kroeze, C. Evaluating Environmental Performance of Concentrated Latex Production in Thailand. J. Clean. Prod. 2015, 98, 84–91. [Google Scholar] [CrossRef]
- Rattanapan, C.; Suksaroj, T.; Ounsaneha, W. Development of Eco-Efficiency Indicators for Rubber Glove Product by Material Flow Analysis. Procedia Soc. Behav. Sci. 2012, 40, 99–106. [Google Scholar] [CrossRef]
- Yew, G.Y.; Tham, T.C.; Show, P.L.; Ho, Y.C.; Ong, S.K.; Law, C.L.; Song, C.; Chang, J.S. Unlocking the Secret of Bio-Additive Components in Rubber Compounding in Processing Quality Nitrile Glove. Appl. Biochem. Biotechnol. 2020, 191, 1–28. [Google Scholar] [CrossRef]
- Kloepfer, A.; Jekel, M.; Reemtsma, T. Occurrence, Sources, and Fate of Benzothiazoles in Municipal Wastewater Treatment Plants. Environ. Sci. Technol. 2005, 39, 3792–3798. [Google Scholar] [CrossRef]
- Lenko, D.; Schlögl, S.; Temel, A.; Schaller, R.; Holzner, A.; Kern, W. Dual Crosslinking of Carboxylated Nitrile Butadiene Rubber Latex Employing the Thiol-Ene Photoreaction. J. Appl. Polym. Sci. 2013, 129, 2735–2743. [Google Scholar] [CrossRef]
- Yew, G.Y.; Tham, T.C.; Law, C.L.; Chu, D.T.; Ogino, C.; Show, P.L. Emerging Crosslinking Techniques for Glove Manufacturers with Improved Nitrile Glove Properties and Reduced Allergic Risks. Mater. Today Commun. 2019, 19, 39–50. [Google Scholar] [CrossRef]
- Nik Yahya, N.Z.; Zulkepli, N.N.; Ismail, H.; Ting, S.S.; Abdullah, M.M.A.B.; Kamarudin, H.; Hamzah, R. Properties of Natural Rubber/Styrene Butadiene Rubber/Recycled Nitrile Glove (NR/SBR/RNBRg) Blends: The Effects of Recycled Nitrile Glove (RNBRg) Particle Sizes. Key Eng. Mater. 2016, 673, 151–160. [Google Scholar] [CrossRef]
- Linos, A.; Reichelt, R.; Keller, U.; Steinbüchel, A. A Gram-Negative Bacterium, Identified as Pseudomonas Aeruginosa AL98, Is a Potent Degrader of Natural Rubber and Synthetic Cis-1,4-Polyisoprene. FEMS Microbiol. Lett. 2000, 182, 155–161. [Google Scholar] [CrossRef]
- Rose, K.; Steinbüchel, A. Biodegradation of Natural Rubber and Related Compounds: Recent Insights into a Hardly Understood Catabolic Capability of Microorganisms. Appl. Environ. Microbiol. 2005, 71, 2803–2812. [Google Scholar] [CrossRef]
- Chengalroyen, M.D.; Dabbs, E.R. The Biodegradation of Latex Rubber: A Minireview. J. Polym. Environ. 2013, 21, 874–880. [Google Scholar] [CrossRef]
- Arenskötter, M.; Baumeister, D.; Berekaa, M.; Pötter, G.; Kroppenstedt, R.M.; Linos, A.; Steinbüchel, A. Taxonomic Characterization of Two Rubber Degrading Bacteria Belonging to the Species Gordonia Polyisoprenivorans and Analysis of Hyper Variable Regions of 16S RDNA Sequences. FEMS Microbiol. Lett. 2001, 205, 277–282. [Google Scholar] [CrossRef]
- Preece, D.; Lewis, R.; Carré, M.J. A Critical Review of the Assessment of Medical Gloves. Tribol.-Mater. Surf. Interfaces 2021, 15, 10–19. [Google Scholar] [CrossRef]
- Mooibroek, H.; Cornish, K. Alternative Sources of Natural Rubber. Appl. Microbiol. Biotechnol. 2000, 53, 355–365. [Google Scholar] [CrossRef]
- Cacioli, P. Introduction to Latex and the Rubber Industry. Rev. Fr. Allergol. Immunol. Clin. 1997, 37, 1173–1176. [Google Scholar] [CrossRef]
- Das, D.; Nag, S.; Naskar, H.; Acharya, S.; Bakchi, S.; Ali, S.S.; Roy, R.B.; Tudu, B.; Bandyopadhyay, R. Personal Protective Equipment for COVID-19: A Comprehensive Review. In Healthcare Informatics for Fighting COVID-19 and Future Epidemics. EAI/Springer Innovations in Communication and Computing; Garg, L., Chakraborty, C., Mahmoudi, S., Sohmen, V.S., Eds.; Springer: Cham, Switzerland, 2022; pp. 141–154. ISBN 978-3-030-72751-2. [Google Scholar]
- Hänninen, A.R.; Mikkola, J.H.; Kalkkinen, N.; Turjanmaa, K.; Ylitalo, L.; Reunala, T.; Palosuo, T. Increased Allergen Production in Turnip (Brassica Rapa) by Treatments Activating Defense Mechanisms. J. Allergy Clin. Immunol. 1999, 104, 194–201. [Google Scholar] [CrossRef] [PubMed]
- Mercurio, J. Creating a Latex-Safe Perioperative Environment. OR Nurse 2011, 5, 18–25. [Google Scholar] [CrossRef]
- Charous, B.L.; Tarlo, S.M.; Charous, M.A.; Kelly, K. Natural Rubber Latex Allergy in the Occupational Setting. Methods 2002, 27, 15–21. [Google Scholar] [CrossRef] [PubMed]
- Liberatore, K.; Kelly, K.J. Latex Allergy Risks Live On. J. Allergy Clin. Immunol. Pract. 2018, 6, 1877–1878. [Google Scholar] [CrossRef]
- McMillan, F.M. The Chain Straighteners, 1st ed.; The MacMillan Press Ltd.: New York, NY, USA, 1979; ISBN 978-1-349-04432-0. [Google Scholar]
- Zetune, K.; Dombrowski, R.; Day, J.; Wagner, N.J. Puncture and/or Cut Resistant Glove Having Maximized Dexterity, Tactility, and Comfort. U.S. Patent 13/639,740, 6 June 2013. [Google Scholar]
- Cuillo, P.A.; Hewitt, N. The Rubber Formulary; Noyes Publications: Norwich, NY, USA; William Andrew Publishing, LLC: Norwich, NY, USA, 1999; ISBN 0-8155-1434-4. [Google Scholar]
- Konrad, E.; Tschunkur, E. Rubber like Masses from Butadiene Hydrocarbons and Polymerizable Nitrils. U.S. Patent 1,973,000, 11 September 1934. [Google Scholar]
- SmartPractice Polychloroprene Gloves vs Nitrile Gloves: What You Need to Know » SmartPractice Blog. Available online: https://blog.smartpractice.com/polychloroprene-gloves-vs-nitrile-gloves-what-you-need-to-know/ (accessed on 13 March 2023).
- Wypych, G. Handbook of Polymers, 2nd ed.; ChemTec Publishing: Toronto, ON, Canada, 2016; ISBN 9781895198928. [Google Scholar]
- Sugiura, K.; Sugiura, M.; Shiraki, R.; Hayakawa, R.; Shamoto, M.; Sasaki, K.; Itoh, A. Contact Urticaria Due to Polyethylene Gloves. Contact Dermat. 2002, 46, 262–266. [Google Scholar] [CrossRef] [PubMed]
- Carroll, W.F.; Johnson, R.W.; Moore, S.S.; Paradis, R.A. Poly(Vinyl Chloride). In Applied Plastics Engineering Handbook: Processing, Materials, and Applications, 2nd ed.; William Andrew Publishing: Norwich, NY, USA, 2017; pp. 73–89. ISBN 9780323390408. [Google Scholar]
- Tapia-Fuentes, J.; Cruz-Salas, A.; Álvarez-Zeferino, C.; Martínez-Salvador, C.; Pérez-Aragón, B.; Vázquez-Morillas, A. Bioplastics in Personal Protective Equipment. Biodegrad. Mater. Appl. 2022, 173–210. [Google Scholar] [CrossRef]
- Gnaneswaran, V.; Mudhunuri, B.; Bishu, R.R. A Study of Latex and Vinyl Gloves: Performance versus Allergy Protection Properties. Int. J. Ind. Ergon. 2008, 38, 171–181. [Google Scholar] [CrossRef]
- Wallemacq, P.E.; Capron, A.; Vanbinst, R.; Boeckmans, E.; Gillard, J.; Favier, B. Permeability of 13 Different Gloves to 13 Cytotoxic Agents under Controlled Dynamic Conditions. Am. J. Health-Syst. Pharm. 2006, 63, 547–556. [Google Scholar] [CrossRef]
- Landeck, L.; Gonzalez, E.; Koch, O.M. Handling Chemotherapy Drugs—Do Medical Gloves Really Protect? Int. J. Cancer 2015, 137, 1800–1805. [Google Scholar] [CrossRef]
- ASTM D3578-19; Standard Specification for Rubber Examination Gloves. ASTM International: West Conshohocken, PA, USA, 2019; pp. 1–5. [CrossRef]
- ASTM D6319-19; Standard Specification for Nitrile Examination Gloves for Medical Application. ASTM International: West Conshohocken, PA, USA, 2019; pp. 1–4. [CrossRef]
- ASTM D6977-19; Standard Specification for Polychloroprene Examination Gloves for Medical Application. ASTM International: West Conshohocken, PA, USA, 2019; pp. 1–4. [CrossRef]
- EN 455-2:2015; Medical Gloves for Single Use—Part 2: Requirements and Testing for Physical Properties. European Committee for Standardization: Brussels, Belgium, 2015; pp. 1–13.
- Kossan Rubber Industries Bhd Rubber Disposable Gloves. Available online: https://kossan.com.my/products/gloves/healthcare.html (accessed on 18 October 2022).
- Jayathilaka, I.; Ariyadasa, T.U.; Egodage, S.M. Powdered Corn Grain and Cornflour on Properties of Natural Rubber Latex Vulcanizates: Effect of Filler Loading. In Proceedings of the MERCon 2018—4th International Multidisciplinary Moratuwa Engineering Research Conference, Moratuwa, Sri Lanka, 30 May–1 June 2018; pp. 235–240. [Google Scholar] [CrossRef]
- McDonnell, G.; Russell, A.D. Antiseptics and Disinfectants: Activity, Action, and Resistance. Clin. Microbiol. Rev. 1999, 12, 147–179. [Google Scholar] [CrossRef]
- Kenawy, E.-R. Electrospun Polymer Nanofibers with Antimicrobial Activities. In Polymeric Materials with Antimicrobial Activity: From Synthesis to Applications; Muñoz-Bonilla, A., Cerrada, M.L., Fernández-García, M., Eds.; Royal Society of Chemistry: London, UK, 2013; pp. 208–223. [Google Scholar]
- Riyajan, S.A.; Chaiponban, S.; Tanbumrung, K. Investigation of the Preparation and Physical Properties of a Novel Semi-Interpenetrating Polymer Network Based on Epoxised NR and PVA Using Maleic Acid as the Crosslinking Agent. Chem. Eng. J. 2009, 153, 199–205. [Google Scholar] [CrossRef]
- Zhang, H.M.; Wakisaka, N.; Maeda, O.; Yamamoto, T. Vitamin C Inhibits the Growth of a Bacterial Risk Factor for Gastric Carcinoma: Helicobacter Pylori. Cancer 2000, 80, 1897–1903. [Google Scholar] [CrossRef]
- Sánchez-Najera, R.I.; Nakagoshi-Cepeda, S.; Martínez-Sanmiguel, J.J.; Hernandez-Delgadillo, R.; Cabral-Romero, C. Ascorbic Acid On Oral Microbial Growth and Biofilm Formation. Pharma Innov. J. 2013, 2, 103–109. [Google Scholar]
- Vilchèze, C.; Hartman, T.; Weinrick, B.; Jacobs, W.R. Mycobacterium Tuberculosis Is Extraordinarily Sensitive to Killing by a Vitamin C-Induced Fenton Reaction. Nat. Commun. 2013, 4, 1–10. [Google Scholar] [CrossRef]
- Biswas, S.; Thomas, N.; Mandal, A.; Mullick, A.; Chandra, D.; Mukherjee, S.; Sett, S.; Kumar Mitra, A. In Vitro Analysis of Antibacterial Activity of Vitamin C alone and in Combination with Antibiotics on Gram Positive Rod isolated from Soil of a Dumping Site of Kolkata. Int. J. Pharm. Biol. Sci. 2013, 3, 101–110. [Google Scholar]
- El-Gebaly, E.; Essam, T.; Hashem, S.; El-Baky, R.A. Effect of Levofloxacin and Vitamin C on Bacterial Adherence and Preformed Biofilm on Urethral Catheter Surfaces. J. Microb. Biochem. Technol. 2012, 4, 131–136. [Google Scholar] [CrossRef]
- Verghese, R.; Mathew, S.; David, A. Antimicrobial Activity of Vitamin C Demonstrated on Uropathogenic Escherichia Coli and Klebsiella Pneumoniae. J. Curr. Res. Sci. Med. 2017, 3, 88. [Google Scholar] [CrossRef]
- Riyajan, S. ad Biodegradable Green Glove Containing Ascorbic Acid from Maleated Epoxidized Natural Rubber/Poly(Vinyl Alcohol) Blend: Preparation and Physical Properties. J. Polym. Environ. 2022, 30, 1141–1150. [Google Scholar] [CrossRef]
- Mohammed, L.; Ansari, M.N.M.; Pua, G.; Jawaid, M.; Islam, M.S. A Review on Natural Fiber Reinforced Polymer Composite and Its Applications. Int. J. Polym. Sci. 2015, 2015, 243947. [Google Scholar] [CrossRef]
- Thomas, S.K.; Parameswaranpillai, J.; Krishnasamy, S.; Begum, P.M.S.; Nandi, D.; Siengchin, S.; George, J.J.; Hameed, N.; Salim, N.V.; Sienkiewicz, N. A Comprehensive Review on Cellulose, Chitin, and Starch as Fillers in Natural Rubber Biocomposites. Carbohydr. Polym. Technol. Appl. 2021, 2, 100095. [Google Scholar] [CrossRef]
- Bode, H.B.; Kerkhoff, K.; Jendrossek, D. Bacterial Degradation of Natural and Synthetic Rubber. Biomacromolecules 2001, 2, 295–303. [Google Scholar] [CrossRef]
- Afiq, M.M.; Azura, A.R. Effect of Sago Starch Loadings on Soil Decomposition of Natural Rubber Latex (NRL) Composite Films Mechanical Properties. Int. Biodeterior. Biodegradation 2013, 85, 139–149. [Google Scholar] [CrossRef]
- Taghvaei-Ganjali, S.; Motiee, F.; Shakeri, E.; Abbasian, A. Effect of Amylose/Amylopectin Ratio on Physico-Mechanical Properties of Rubber Compounds Filled by Starch. J. Appl. Chem. Res. 2010, 4, 53–60. [Google Scholar]
- Wei, B.; Xu, X.; Jin, Z.; Tian, Y. Surface Chemical Compositions and Dispersity of Starch Nanocrystals Formed by Sulfuric and Hydrochloric Acid Hydrolysis. PLoS ONE 2014, 9, e86024. [Google Scholar] [CrossRef] [PubMed]
- Abiola, C.; Oyetayo, V.O. Isolation and Biochemical Characterization of Microorganisms Associated with the Fermentation of Kersting’s Groundnut (Macrotyloma Geocarpum). Res. J. Microbiol. 2016, 11, 47–55. [Google Scholar] [CrossRef]
- Riscoe, M.; Kelly, J.X.; Winter, R. Xanthones as Antimalarial Agents: Discovery, Mode of Action, and Optimization. Curr. Med. Chem. 2005, 12, 2539–2549. [Google Scholar] [CrossRef]
- Pedraza-Chaverri, J.; Cárdenas-Rodríguez, N.; Orozco-Ibarra, M.; Pérez-Rojas, J.M. Medicinal Properties of Mangosteen (Garcinia Mangostana). Food Chem. Toxicol. 2008, 46, 3227–3239. [Google Scholar] [CrossRef]
- Moopayak, W.; Tangboriboon, N. Mangosteen Peel and Seed as Antimicrobial and Drug Delivery in Rubber Products. J. Appl. Polym. Sci. 2020, 137, 49119. [Google Scholar] [CrossRef]
- Cao, L.; Yuan, D.; Fu, X.; Chen, Y. Green Method to Reinforce Natural Rubber with Tunicate Cellulose Nanocrystals via One-Pot Reaction. Cellulose 2018, 25, 4551–4563. [Google Scholar] [CrossRef]
- Ding, C.; Matharu, A.S. Recent Developments on Biobased Curing Agents: A Review of Their Preparation and Use. ACS Sustain. Chem. Eng. 2014, 2, 2217–2236. [Google Scholar] [CrossRef]
- Lee, H.V.; Hamid, S.B.A.; Zain, S.K. Conversion of Lignocellulosic Biomass to Nanocellulose: Structure and Chemical Process. Sci. World J. 2014, 2014, 631013. [Google Scholar] [CrossRef]
- Panchal, P.; Ogunsona, E.; Mekonnen, T. Trends in Advanced Functional Material Applications of Nanocellulose. Processes 2018, 7, 10. [Google Scholar] [CrossRef]
- Parambath Kanoth, B.; Claudino, M.; Johansson, M.; Berglund, L.A.; Zhou, Q. Biocomposites from Natural Rubber: Synergistic Effects of Functionalized Cellulose Nanocrystals as Both Reinforcing and Cross-Linking Agents via Free-Radical Thiol-Ene Chemistry. ACS Appl. Mater. Interfaces 2015, 7, 16303–16310. [Google Scholar] [CrossRef] [PubMed]
- Blanchard, R.; Ogunsona, E.O.; Hojabr, S.; Berry, R.; Mekonnen, T.H. Synergistic Cross-Linking and Reinforcing Enhancement of Rubber Latex with Cellulose Nanocrystals for Glove Applications. ACS Appl. Polym. Mater. 2020, 2, 887–898. [Google Scholar] [CrossRef]
- Thakore, S. Nanosized Cellulose Derivatives as Green Reinforcing Agents at Higher Loadings in Natural Rubber. J. Appl. Polym. Sci. 2014, 131, 1–7. [Google Scholar] [CrossRef]
- Reitzel, R.A.; Dvorak, T.L.; Hachem, R.Y.; Fang, X.; Jiang, Y.; Raad, I. Efficacy of Novel Antimicrobial Gloves Impregnated with Antiseptic Dyes in Preventing the Adherence of Multidrug-Resistant Nosocomial Pathogens. Am. J. Infect. Control. 2009, 37, 294–300. [Google Scholar] [CrossRef] [PubMed]
- Koburger, T.; Hübner, N.O.; Braun, M.; Siebert, J.; Kramer, A. Standardized Comparison of Antiseptic Efficacy of Triclosan, PVP-Iodine, Octenidine Dihydrochloride, Polyhexanide and Chlorhexidine Digluconate. J. Antimicrob. Chemother. 2010, 65, 1712–1719. [Google Scholar] [CrossRef] [PubMed]
- Peng, J.; Liu, P.; Peng, W.; Sun, J.; Dong, X.; Ma, Z.; Gan, D.; Liu, P.; Shen, J. Poly(Hexamethylene Biguanide) (PHMB) as High-Efficiency Antibacterial Coating for Titanium Substrates. J. Hazard. Mater. 2021, 411, 125110. [Google Scholar] [CrossRef]
- Sowlati-Hashjin, S.; Karttunen, M.; Carbone, P. Insights into the Polyhexamethylene Biguanide (PHMB) Mechanism of Action on Bacterial Membrane and DNA: A Molecular Dynamics Study. J. Phys. Chem. B 2020, 124, 4487–4497. [Google Scholar] [CrossRef]
- Leitgeb, J.; Schuster, R.; Eng, A.H.; Yee, B.N.; Teh, Y.P.; Dosch, V.; Assadian, O. In-Vitro Experimental Evaluation of Skin-to-Surface Recovery of Four Bacterial Species by Antibacterial and Non-Antibacterial Medical Examination Gloves. Antimicrob. Resist. Infect. Control. 2013, 2, 27. [Google Scholar] [CrossRef]
- Daeschlein, G.; Kramer, A.; Arnold, A.; Ladwig, A.; Seabrook, G.R.; Edmiston, C.E. Evaluation of an Innovative Antimicrobial Surgical Glove Technology to Reduce the Risk of Microbial Passage Following Intraoperative Perforation. Am. J. Infect. Control. 2011, 39, 98–103. [Google Scholar] [CrossRef]
- Vongsetskul, T.; Wongsomboon, P.; Sunintaboon, P.; Tantimavanich, S.; Tangboriboonrat, P. Antimicrobial Nitrile Gloves Coated by Electrospun Trimethylated Chitosan-Loaded Polyvinyl Alcohol Ultrafine Fibers. Polym. Bull. 2015, 72, 2285–2296. [Google Scholar] [CrossRef]
- Raafat, D.; Von Bargen, K.; Haas, A.; Sahl, H.G. Insights into the Mode of Action of Chitosan as an Antibacterial Compound. Appl. Environ. Microbiol. 2008, 74, 3764–3773. [Google Scholar] [CrossRef]
- Kong, M.; Chen, X.G.; Xing, K.; Park, H.J. Antimicrobial Properties of Chitosan and Mode of Action: A State of the Art Review. Int. J. Food Microbiol. 2010, 144, 51–63. [Google Scholar] [CrossRef]
- Schrank, C.L.; Minbiole, K.P.C.; Wuest, W.M. Are Quaternary Ammonium Compounds, the Workhorse Disinfectants, Effective against Severe Acute Respiratory Syndrome-Coronavirus-2? ACS Infect. Dis. 2020, 6, 1553–1557. [Google Scholar] [CrossRef] [PubMed]
- Arakkal, A.; Rathinam, P.; Sirajunnisa, P.; Gopinathan, H.; Vengellur, A.; Bhat, S.G.; Sailaja, G.S. Antibacterial Natural Rubber Latex Films with Surface-Anchored Quaternary Poly(4-Vinylpyridine) Polyelectrolyte. React. Funct. Polym. 2022, 172, 105190. [Google Scholar] [CrossRef]
- Zhuo, Y.; Cheng, X.; Fang, H.; Zhang, Y.; Wang, B.; Jia, S.; Li, W.; Yang, X.; Zhang, Y.; Wang, X. Medical Gloves Modified by a One-Minute Spraying Process with Blood-Repellent, Antibacterial and Wound-Healing Abilities. Biomater. Sci. 2022, 10, 939–946. [Google Scholar] [CrossRef]
- Chen, Y.; Peng, Z.; Kong, L.X.; Huang, M.F.; Li, P.W. Natural Rubber Nanocomposite Reinforced with Nano Silica. Polym. Eng. Sci. 2008, 48, 1674–1677. [Google Scholar] [CrossRef]
- Mou, W.; Li, J.; Fu, X.; Huang, C.; Chen, L.; Liu, Y. SiO2 and ZnO Hybrid Nanofillers Modified Natural Rubber Latex: Excellent Mechanical and Antibacterial Properties. Polym. Eng. Sci. 2022, 62, 3110–3120. [Google Scholar] [CrossRef]
- Jalal, R.; Goharshadi, E.K.; Abareshi, M.; Moosavi, M.; Yousefi, A.; Nancarrow, P. ZnO Nanofluids: Green Synthesis, Characterization, and Antibacterial Activity. Mater. Chem. Phys. 2010, 121, 198–201. [Google Scholar] [CrossRef]
- Raghupathi, K.R.; Koodali, R.T.; Manna, A.C. Size-Dependent Bacterial Growth Inhibition and Mechanism of Antibacterial Activity of Zinc Oxide Nanoparticles. Langmuir 2011, 27, 4020–4028. [Google Scholar] [CrossRef] [PubMed]
- Leung, Y.H.; Chan, C.M.N.; Ng, A.M.C.; Chan, H.T.; Chiang, M.W.L.; Djurišić, A.B.; Ng, Y.H.; Jim, W.Y.; Guo, M.Y.; Leung, F.C.C.; et al. Antibacterial Activity of ZnO Nanoparticles with a Modified Surface under Ambient Illumination. Nanotechnology 2012, 23, 475703. [Google Scholar] [CrossRef] [PubMed]
- Turner, R.J. Is Silver the Ultimate Antimicrobial Bullet? Antibiotics 2018, 7, 112. [Google Scholar] [CrossRef]
- Bedlovičová, Z.; Salayová, A. Green-Synthesized Silver Nanoparticles and Their Potential for Antibacterial Applications. Bact. Pathog. Antibact. Control. 2018, 12, 73–94. [Google Scholar] [CrossRef]
- More, P.R.; Pandit, S.; De Filippis, A.; Franci, G.; Mijakovic, I.; Galdiero, M. Silver Nanoparticles: Bactericidal and Mechanistic Approach against Drug Resistant Pathogens. Microorganisms 2023, 11, 369. [Google Scholar] [CrossRef]
- Paosen, S.; Lethongkam, S.; Wunnoo, S.; Lehman, N.; Kalkornsurapranee, E.; Septama, A.W.; Voravuthikunchai, S.P. Prevention of Nosocomial Transmission and Biofilm Formation on Novel Biocompatible Antimicrobial Gloves Impregnated with Biosynthesized Silver Nanoparticles Synthesized Using Eucalyptus Citriodora Leaf Extract. Biotechnol. J. 2021, 16, e2100030. [Google Scholar] [CrossRef]
- Airey, P.; Verran, J. Potential Use of Copper as a Hygienic Surface; Problems Associated with Cumulative Soiling and Cleaning. J. Hosp. Infect. 2007, 67, 271–277. [Google Scholar] [CrossRef]
- Casey, A.L.; Adams, D.; Karpanen, T.J.; Lambert, P.A.; Cookson, B.D.; Nightingale, P.; Miruszenko, L.; Shillam, R.; Christian, P.; Elliott, T.S.J. Role of Copper in Reducing Hospital Environment. J. Hosp. Infect. 2010, 74, 72–77. [Google Scholar] [CrossRef]
- Noyce, J.O.; Michels, H.; Keevil, C.W. Potential Use of Copper Surfaces to Reduce Survival of Epidemic Meticillin-Resistant Staphylococcus Aureus in the Healthcare Environment. J. Hosp. Infect. 2006, 63, 289–297. [Google Scholar] [CrossRef]
- Arendsen, L.P.; Thakar, R.; Sultan, A.H. The Use of Copper as an Antimicrobial Agent in Health Care, Including Obstetrics and Gynecology. Clin. Microbiol. Rev. 2019, 32, 1–28. [Google Scholar] [CrossRef]
- Tripathy, A.; Kumar, A.; Chowdhury, A.R.; Karmakar, K.; Purighalla, S.; Sambandamurthy, V.; Chakravortty, D.; Sen, P. A Nanowire-Based Flexible Antibacterial Surface Reduces the Viability of Drug-Resistant Nosocomial Pathogens. ACS Appl. Nano Mater. 2018, 1, 2678–2688. [Google Scholar] [CrossRef]

| Function | Description |
|---|---|
| pH increasing | Generally, KOH is added to latex to raise its pH to 10–11. |
| Surfactants | Suspensions of chemicals in water can be made more stable with the help of ionic and non-ionic additives. |
| Rosin resins | Some synthetic latexes, such as CR and IR, are formulated with colophonium resins, which effectively perform the functions of particle stability and film forming. |
| Material | Advantages | Disadvantages |
|---|---|---|
| NR | Good resistance to alkali and acids. Comfortable, good fitting and feeling for hands. High elasticity and ability to adapt to shapes. High tear strength. Waterproof. | Permeable to several solvents. Poor resistance to chemicals. Possible allergies due to residual protein. |
| IR | Absence of allergy associated with proteins in NR gloves. Good elasticity and break resistance. | It is costly. |
| NBR | Good alternative for people that are allergic to NR gloves. Resistance to various chemicals, especially oils, fuels, weak acids, caustics, and some organic solvents. Eligible for handling most food materials. Good resistance to mechanical stress. | It has a low level of sensitivity, which may restrict how well the hands adapt to and operate with the gloves. Low resistance to alcohols, amines, ketones, ester, ethers, concentrated acids, halogenated hydrocarbons, and aromatic hydrocarbons. |
| CR | Resistance to temperature and harsh chemicals. Mechanical and flammability resistance are superior to NBR gloves. CR gloves fit and feel like NR gloves. Appropriate for people allergic to NR. | It is costly. |
| PE | Can be used for food material. Inexpensive option. | Poor resistance and barrier protection. |
| PVC | It is cost-effective, since PVC is inexpensive. Good for those suffering from skin and chemical allergies as it is skin-friendly. | Due to plasticizer, not adequate for handling fatty food since there is the possibility of migration of the plasticizer into the food. Less stretch, comfort, and elongation than NR. Poor resistance to chemical degradation. High permeability to chemotherapy drugs. |
| Property of Examination Gloves | ASTM D3578—19 (NR) [68] | ASTM D6319—19 (NBR) [69] | ASTM D6977—19 (CR) [70] | |||||
|---|---|---|---|---|---|---|---|---|
| Before Aging | After Aging | Before Aging | After Aging | Before Aging | After Aging | |||
| Type I | Type II | Type I | Type II | |||||
| Minimum Tensile Strength (MPa) | 18 | 14 | 14 | 14 | 14 | 14 | 14 | 14 |
| Maximum Stress at 500% Elongation (MPa) | 5.5 | 2.8 | - | - | - | - | - | - |
| Minimum Ultimate Elongation (%) | 650 | 650 | 500 | 500 | 500 | 400 | 500 | 400 |
| Property | Latex Examination Glove PS60Y | Nitrile Examination Glove CS30 | ||
|---|---|---|---|---|
| Unaged | Aged | Unaged | Aged | |
| Tensile Strength (MPa) | 20–24 | 16–20 | 28–32 | 29–33 |
| Ultimate Elongation (%) | 700–740 | 600–640 | 500–540 | 460–500 |
| Force at Break (N) | 7.0–7.5 | 7.0–7.5 | 6.0–6.3 | 6.0–6.3 |
| Microorganisms Tested | U0 (cfu/cm2) | Ut (cfu/cm2) | At (cfu/cm2) | R | Antibacterial Rate (%) |
|---|---|---|---|---|---|
| E. coli | 2.1 × 104 | 2.9 × 105 | <0.6 | >5.3 | >99.9 |
| S. aureus | 2.1 × 104 | 2.3 × 105 | <0.6 | >5.2 | >99.9 |
Disclaimer/Publisher’s Note: The statements, opinions and data contained in all publications are solely those of the individual author(s) and contributor(s) and not of MDPI and/or the editor(s). MDPI and/or the editor(s) disclaim responsibility for any injury to people or property resulting from any ideas, methods, instructions or products referred to in the content. |
© 2023 by the authors. Licensee MDPI, Basel, Switzerland. This article is an open access article distributed under the terms and conditions of the Creative Commons Attribution (CC BY) license (https://creativecommons.org/licenses/by/4.0/).
Share and Cite
Lovato, M.J.; del Valle, L.J.; Puiggalí, J.; Franco, L. Performance-Enhancing Materials in Medical Gloves. J. Funct. Biomater. 2023, 14, 349. https://doi.org/10.3390/jfb14070349
Lovato MJ, del Valle LJ, Puiggalí J, Franco L. Performance-Enhancing Materials in Medical Gloves. Journal of Functional Biomaterials. 2023; 14(7):349. https://doi.org/10.3390/jfb14070349
Chicago/Turabian StyleLovato, María José, Luis J. del Valle, Jordi Puiggalí, and Lourdes Franco. 2023. "Performance-Enhancing Materials in Medical Gloves" Journal of Functional Biomaterials 14, no. 7: 349. https://doi.org/10.3390/jfb14070349
APA StyleLovato, M. J., del Valle, L. J., Puiggalí, J., & Franco, L. (2023). Performance-Enhancing Materials in Medical Gloves. Journal of Functional Biomaterials, 14(7), 349. https://doi.org/10.3390/jfb14070349

